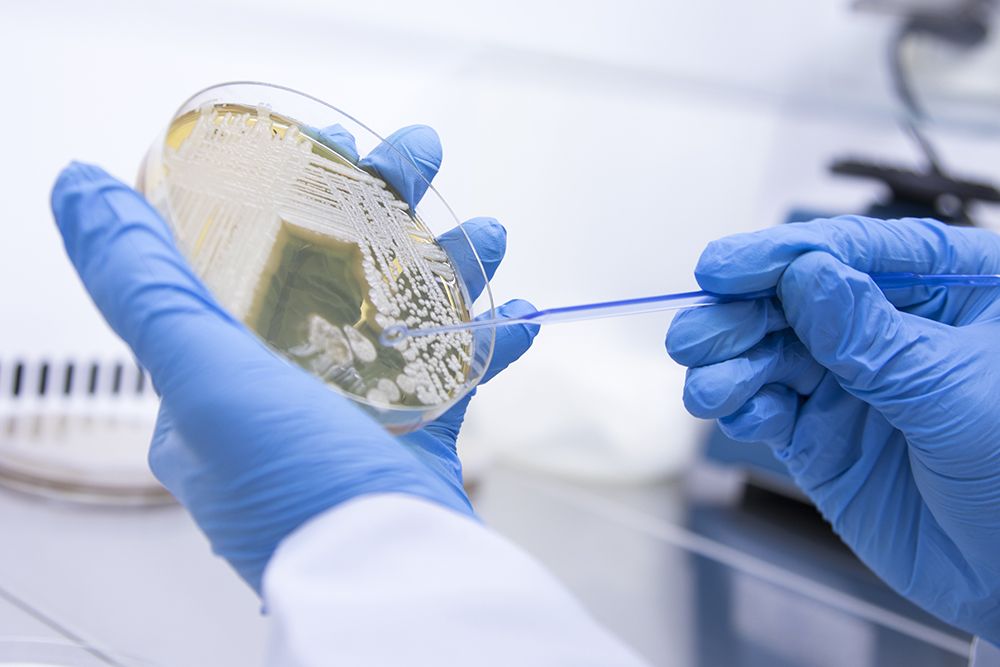
Bioburden Testing Market: Unveiling Growth Dynamics

The Bioburden Testing Market is witnessing a steady surge in demand driven by stringent regulatory requirements, technological advancements, and increasing awareness regarding the importance of microbial contamination control in pharmaceutical and medical device manufacturing processes. Bioburden testing, a critical component of quality control, ensures the safety and efficacy of healthcare products. This report delves into the various factors influencing the Bioburden Testing Market, including market drivers, PEST analysis, and SWOT analysis.
Market Drivers:
The Bioburden Testing Market is propelled by several key factors. Firstly, the escalating emphasis on maintaining product quality and safety standards in the pharmaceutical and medical device industries is driving the demand for bioburden testing services and products. Stringent regulatory requirements, such as those outlined by regulatory bodies like the FDA and EMA, mandate thorough bioburden testing to ensure compliance with Good Manufacturing Practices (GMP) and other quality standards. Additionally, the rising incidence of healthcare-associated infections (HAIs) underscores the importance of effective bioburden testing in preventing microbial contamination, thereby bolstering market growth.
PEST Analysis:
A PEST analysis provides insights into the external factors influencing the Bioburden Testing Market Size. Political factors, including regulatory frameworks and government policies related to healthcare and pharmaceutical manufacturing, significantly impact market dynamics. Economic factors such as healthcare expenditure and budget allocations for quality control measures also shape the market landscape. Socio-cultural trends, such as increasing awareness among consumers regarding product safety and quality, drive demand for stringent bioburden testing protocols. Furthermore, technological advancements and innovations in bioburden testing methodologies represent significant opportunities for market expansion.
SWOT Analysis:
A SWOT analysis further elucidates the strengths, weaknesses, opportunities, and threats within the Bioburden Testing Market. Key strengths include the critical role of bioburden testing in ensuring product quality and safety, as well as the growing adoption of automated and rapid microbial detection technologies, enhancing testing efficiency. However, weaknesses such as the high cost associated with advanced bioburden testing equipment and the complexity of regulatory compliance pose challenges to market growth. Opportunities lie in the development of novel testing methodologies and the expansion of bioburden testing services in emerging markets. Nevertheless, threats such as the emergence of antimicrobial-resistant microorganisms and the potential for regulatory changes affecting testing requirements necessitate ongoing vigilance within the market.
The Bioburden Testing Market is poised for significant growth driven by factors such as stringent regulatory requirements, increasing awareness of product quality and safety, and technological advancements in microbial detection. A comprehensive understanding of market drivers, coupled with PEST and SWOT analyses, provides valuable insights into the opportunities and challenges shaping the Bioburden Testing Market landscape. As the importance of microbial contamination control continues to escalate across various industries, the demand for bioburden testing solutions is expected to witness sustained growth, positioning the market for continued expansion in the foreseeable future.


















